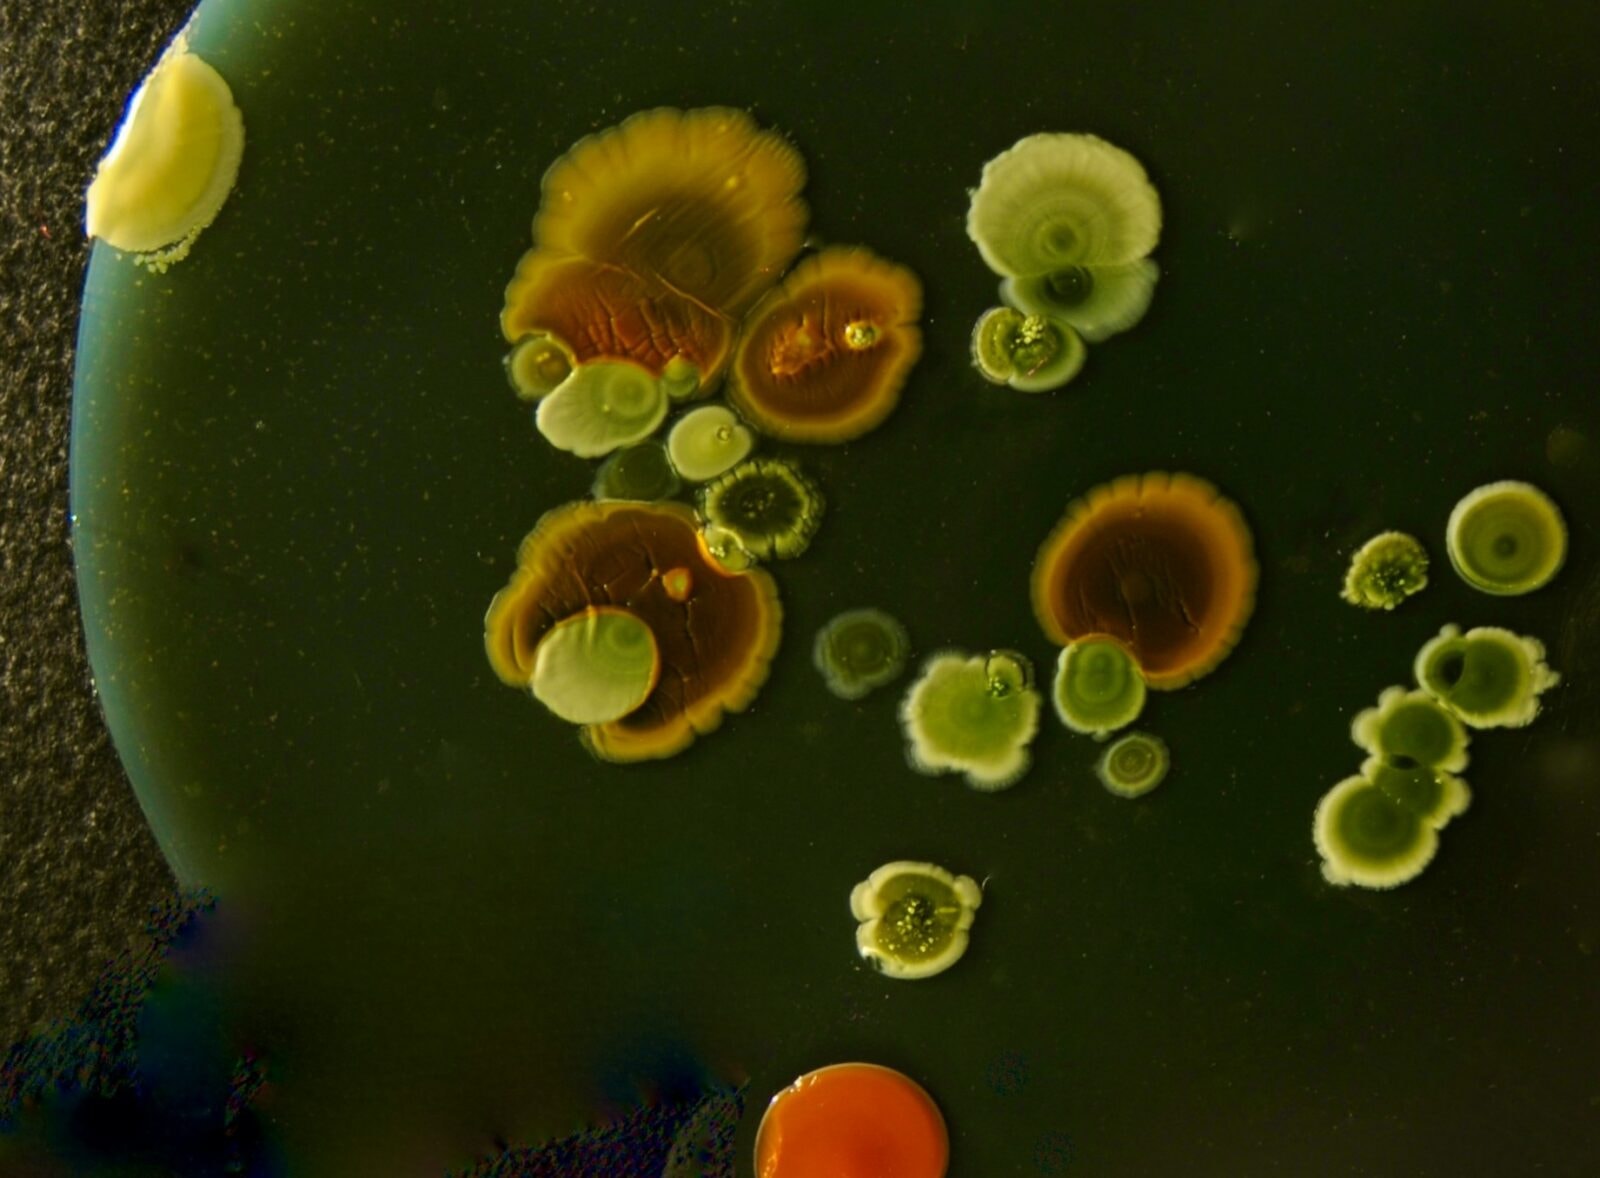
Kolonie bakterii /Fot. Unsplash

Najnowsze pomiary wykonane na pojedynczej bakterii pokazują, że ten naturalny mechanizm jest nie tylko efektowny, ale i fizycznie wystarczająco silny, by działać niezawodnie w realnym świecie.
Bakteria, która nie błądzi na ślepo
W wilgotnych osadach, strefach przydennych i w wodach, gdzie warunki potrafią zmieniać się na przestrzeni centymetrów, liczy się kierunek. Dla mikroorganizmów to nie jest filozoficzna kwestia, tylko koszt energetyczny. Jeśli pływasz chaotycznie, tracisz czas, a czas w mikroskali jest zasobem równie brutalnym jak tlen.
Tu wchodzi magnetotaksja. Bakteria nie tyle podejmuje decyzję, co poddaje się fizyce. W jej wnętrzu ułożony jest łańcuch magnetosomów, czyli drobnych magnetycznych ziaren zamkniętych w strukturach błonowych. Całość zachowuje się jak maleńka igła kompasu, która ustawia komórkę równolegle do linii pola magnetycznego. Dzięki temu ruch zyskuje prosty sens: zamiast losowo rozpraszać się w przestrzeni, bakteria porusza się po czymś, co można nazwać magnetyczną autostradą.
Kompas z nanocząstek i pytanie, które długo wisiało w powietrzu
Naukowcy od lat wiedzieli, że magnetosomy istnieją i że bakterie potrafią się ustawiać w polu Ziemi. Problem był bardziej przyziemny: ile dokładnie wynosi magnetyczna siła takiego łańcucha w pojedynczej komórce i jak stabilnie zachowuje się jego orientacja. W praktyce większość wcześniejszych pomiarów dotyczyła całych populacji bakterii, a to zawsze miesza w wynikach: jedne komórki mają dłuższe łańcuchy, inne krótsze, jedne są w lepszej kondycji, inne już nie.

Przełom polega na tym, że udało się zejść do poziomu jednej bakterii i zmierzyć jej właściwości magnetyczne bez zgadywania na podstawie średnich z tłumu. To kluczowe, bo jeśli myślisz o zastosowaniach technologicznych, nie pracujesz ze statystyką, tylko z konkretnymi obiektami, które muszą zachowywać się przewidywalnie.
W eksperymencie pojedynczą bakterię unieruchomiono na ultracienkiej mikrobeamie, czymś w rodzaju sprężynującego wspornika. Następnie obserwowano, jak zmieniają się jej drgania w różnych polach magnetycznych. Brzmi jak laboratoryjna ciekawostka, ale w tych mikrozmianach częstotliwości drgań zapisane są informacje o tym, jak silny jest moment magnetyczny bakterii i jak stabilnie trzyma ona swoją orientację.
Do tego dołożono mikroskopię elektronową i symulacje komputerowe, żeby dopasować fizyczny obraz do tego, co rzeczywiście siedzi w środku komórki. Efekt: precyzyjne oszacowanie, że magnetosomowy łańcuch jest wystarczająco mocny, aby w naturalnych warunkach ustawiać bakterię równolegle do pola magnetycznego Ziemi, a więc dokładnie tak, jak podpowiadała biologiczna intuicja.
Gdzie kończy się spryt natury, a zaczynają ograniczenia?
Najciekawsze jest to, że układ jest stabilny, ale nie niezniszczalny. Bardzo silne zewnętrzne pola mogą zaburzać to ustawienie, co ma znaczenie, jeśli ktoś chce w przyszłości sterować takimi bakteriami jak mikrorobotami. W pewnym sensie dostajemy mapę granic: wiemy, gdzie pole jest jeszcze narzędziem, a gdzie staje się młotkiem, który rozstraja kompas.
W eksperymentach zauważono też, że przy odwracaniu pola część magnetycznych elementów potrafi nagle przeskoczyć orientację, pojedynczo lub małymi grupami. To zachowanie dobrze pasuje do obrazu układu złożonego z wielu nanomagnesów, które wzajemnie na siebie wpływają. W naturze nie jest to problemem, bo pole Ziemi jest zbyt słabe, by wymusić taki scenariusz w tej samej konfiguracji, a bakteria nie jest na stałe przytwierdzona jak w laboratorium. Ale technologicznie to ważny sygnał: sterowanie będzie wymagało delikatności, nie tylko mocy.

Od mikromedycyny po brudną robotę w wodzie
Gdy pojawia się hasło bakterie sterowane magnesem, wyobraźnia automatycznie idzie w stronę medycyny. I słusznie, bo pomysł wykorzystania magnetotaktycznych mikroorganizmów jako nośników, które można naprowadzać, wraca w badaniach regularnie. Problem w tym, że medycyna nie lubi niespodzianek: jeśli obiekt ma dotrzeć do konkretnego miejsca, musisz znać jego parametry lepiej niż tylko w przybliżeniu. Taki pojedynczo-komórkowy pomiar jest więc jak zdjęcie ostre zamiast rozmazanego: nie rozwiązuje wszystkiego, ale wreszcie pozwala projektować systemy na twardych liczbach.
Drugi kierunek jest bardziej przyziemny, ale może nawet szybciej praktyczny: oczyszczanie wody. Jeżeli bakterie potrafią wiązać określone zanieczyszczenia, a potem można je wyłapać magnesem, to brzmi jak prosty, elegancki trik inżynierski. Tyle że znów wraca ta sama przeszkoda: skalowanie i kontrola. Żeby to działało w instalacji, a nie w prezentacji, trzeba wiedzieć, jak zachowuje się pojedyncza komórka w konkretnym polu, przepływie i środowisku. I właśnie tu takie badania dokładają brakujący klocek.